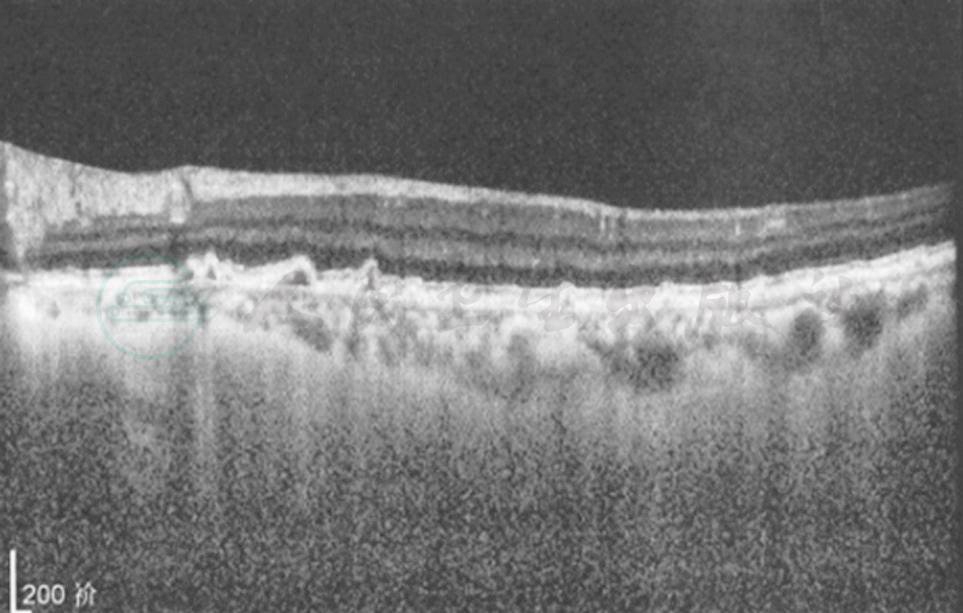

本病为非霍奇金B细胞大淋巴瘤,主要侵犯中枢神经系统与眼的玻璃体及视网膜。近年来发病明显增加,可能与AID病的发病率增加有关,但在我国还与我们对本病认识的提高相关。据复旦大学附属眼耳鼻喉科医院病例,发病年龄在41~84岁间,平均(55.69±12.55)岁。男女无明显差异,可能女性稍高。80%双眼受累。眼部症状往往先于神经系统症状,眼淋巴瘤患者最后85%发生中枢神经系统淋巴瘤,并是导致患者死亡的主要原因。先有中枢神经系统淋巴瘤的患者中,15%~25%以后将发生眼内淋巴瘤,也有两处同时发生的。原发性眼内淋巴瘤的主要症状为无痛性视力下降及飞蚊症。检查以表现单纯玻璃体炎者最多,达50%以上。玻璃体内可见簇状、片状或云雾样灰白色细胞浸润,周边部浓密,向中央渐稀疏,视网膜可无病变。其次为视网膜深层色素上皮下有黄白色、扁平的肿瘤浸润病灶,大小不一,可融合成片,视网膜病变可伴有或不伴玻璃体混浊。上述两种为眼内淋巴瘤的典型表现,非典型表现则多种多样。有沿血管旁浸润,有如树枝挂霜样血管炎;肿瘤侵犯视网膜表现为黄白色的视网膜坏死灶,如同急性视网膜坏死综合征表现;由于色素上皮遭破坏可出现渗出性视网膜脱离;少数情况下也有表现为孤立的眼内肿瘤;瘤细胞如侵犯视盘,则有类似视神经炎或视盘水肿的表现。极少数的情况下肿瘤可自行消退,原病灶处出现斑点状的色素上皮增生或去色素改变。眼前节可有角膜后KP、虹膜结节、房水细胞及闪辉征阳性,这些体征缺乏特异性,但虹膜无后粘连往往提示非葡萄膜炎症。辅助检查方面:B超显示局部球壁隆起或弥漫性球壁增厚,内反射呈低回声。荧光血管造影早期浸润病变呈低荧光,后期呈高荧光,可能伴有血管炎改变。OCT在色素上皮与Bruch膜间有高反射物质为其特征改变(图1)。
图1 OCT示视网膜下肿瘤浸润
单眼眼内淋巴瘤无中枢神经受累的,可考虑眼局部治疗,玻璃体腔注药与外放射是目前的主要方法。药物有甲氨蝶呤(methotrexate,200~400mg/0.1ml)及抗CD20抗体(rituximab,1mg/0.1ml),但需重复注射。甲氨蝶呤的主要并发症有结膜充血、角膜上皮病变与白内障。rituximab则可引起低眼压。淋巴瘤对放射敏感,常用剂量为40Gy,分次照射(分剂量1.5~2.0Gy)。治疗后也常复发。复发病例不宜再作放疗而改化疗。如伴有中枢神经肿瘤,目前多采用大剂量甲氨蝶呤全身化疗或椎管内注入。













